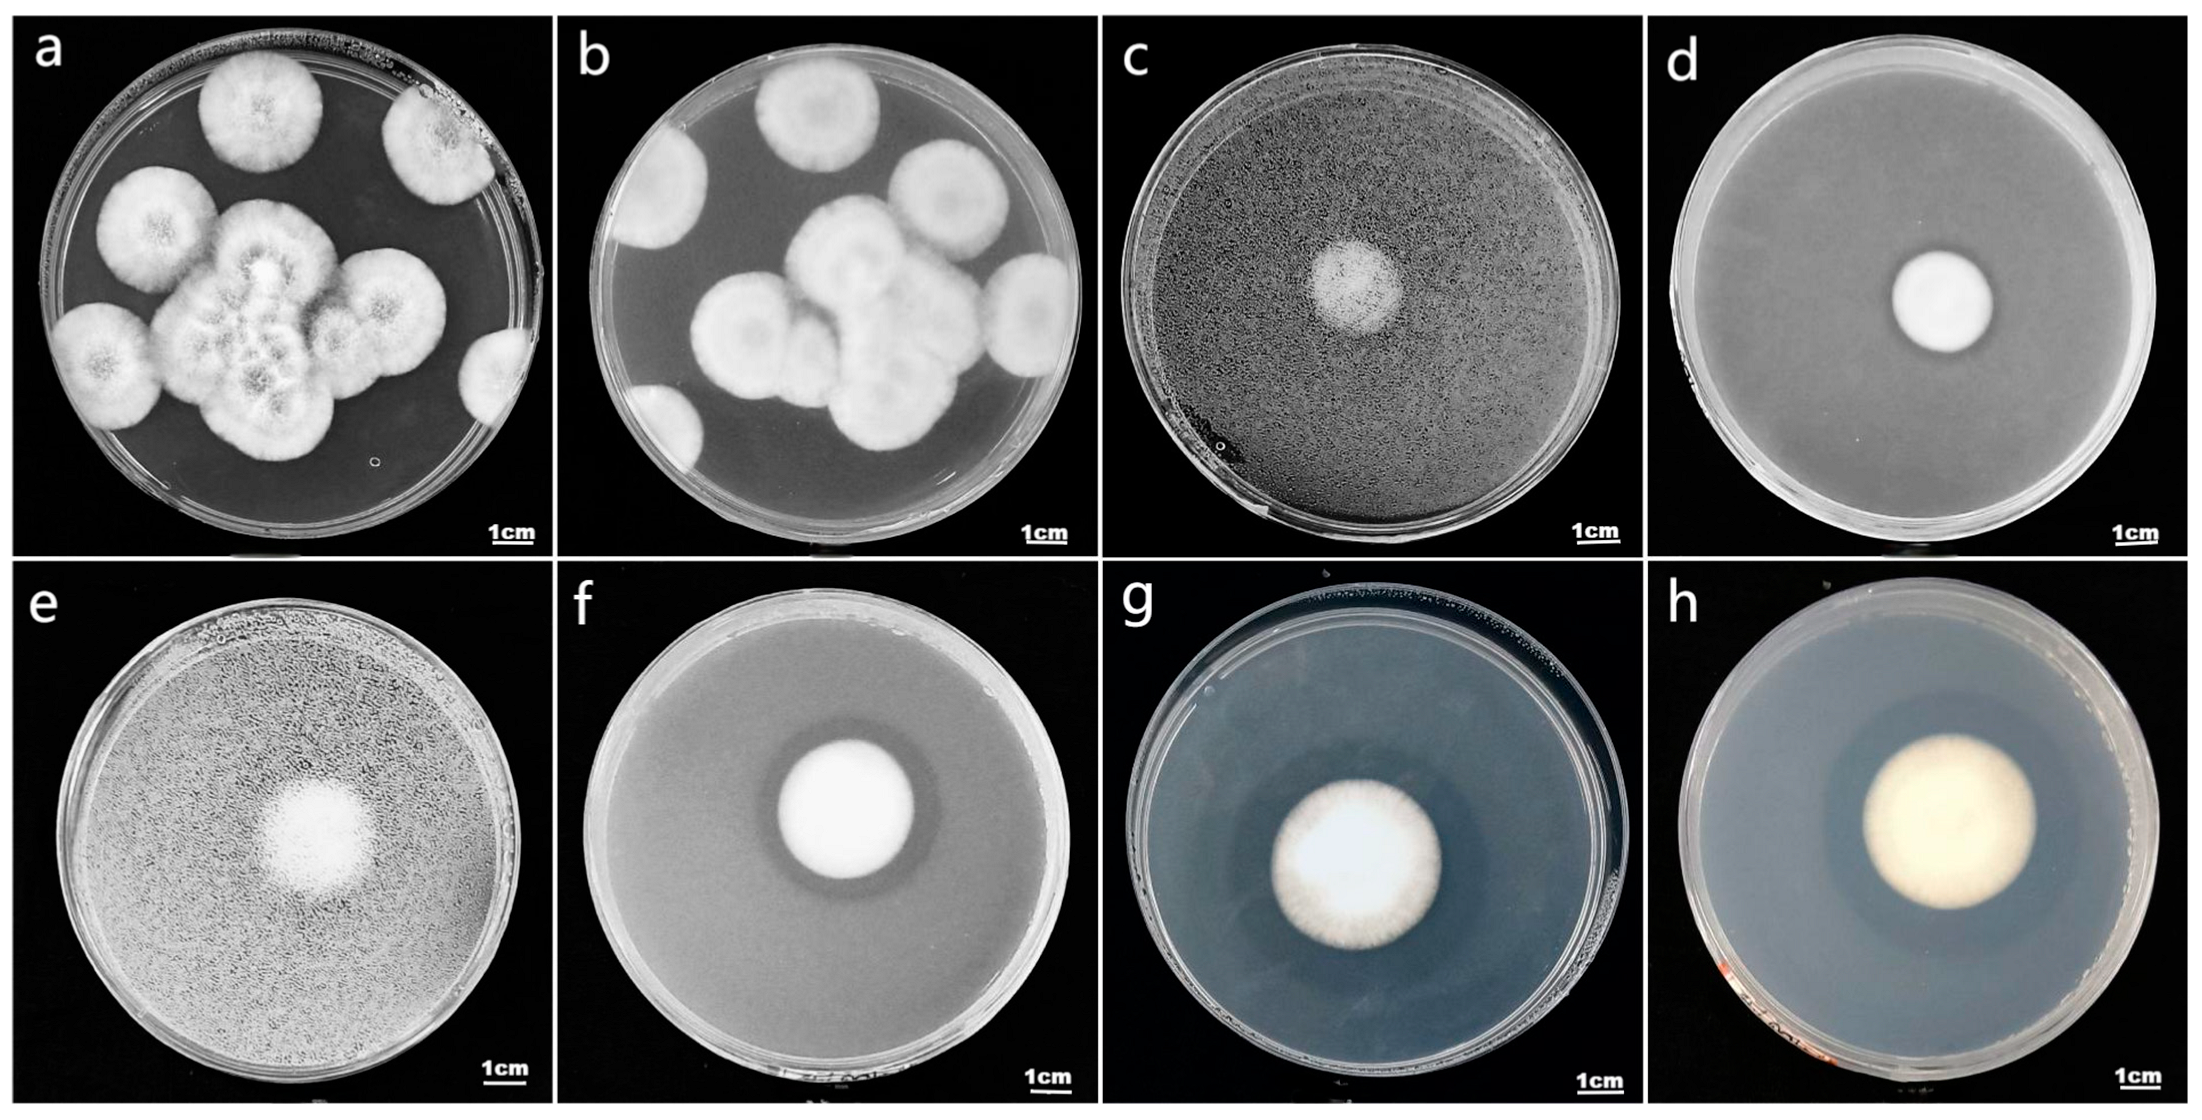
Plants 13 01694 g001

Abstract
I. cateinannulata has been shown to promote the growth of F. tataricum. However, whether its growth-promoting capacity is related to its ability to solubilize phosphorus has not been reported. Therefore, in this study, we sought to assess the phosphorus-solubilizing ability of 18 strains of I. cateinannulata by analyzing their growth in an inorganic phosphorus culture medium. The effects of F. tataricum on growth and effective phosphorus content were analyzed through field experiments. The results showed that all 18 strains of I. cateinannulata had a phosphorus release capacity, with phosphorus solubilization ranging from 5.14 ± 0.37 mg/L to 6.21 ± 0.01 mg/L, and strain 9 exhibited the best phosphorus solubilization effect. Additionally, the field results demonstrated that I. cateinannulata positively influenced the growth, root length, and yield of F. tataricum by increasing the chlorophyll and soluble phosphorus content. This study will provide a material basis and theoretical support for investigating the interaction mechanism between I. cateinannulata and F. tataricum.
1. Introduction
Phosphorus (P) is one of the essential nutrient elements for plant growth and development, accounting for approximately 0.05–0.5% of plant dry weight. It plays a crucial role in various biochemical reactions, serving as an important component of cell structure and composition, and significantly influences crop yield and quality [1,2]. However, phosphorus in soil mainly exists in the form of insoluble organic or inorganic phosphates; less than 5% of available phosphorus can be directly absorbed and utilized by plants [3]. Phosphorus deficiency in soil can lead to various symptoms, such as purple spots on crop leaves and stems, reduced stomatal conductance, restricted regeneration of ribulose-1,5-bisphosphate carboxylase/oxygenase (RuBP), decreased photosynthetic rate, abnormal carbon and nitrogen metabolism, accumulation of carbohydrates, and inhibition of protein synthesis [4,5,6,7,8,9]. In severe cases, it can significantly reduce crop yield [2].
F. tataricum (L.) Gaertn, commonly known as Tartary buckwheat, is a dicotyledonous plant belonging to the family Polygonaceae, possessing characteristics such as cold and cool tolerance, poor soil tolerance, and a relatively short growth period. Moreover, it contains balanced amino acids, trace elements, dietary fibers, and other rich active substances that contribute to enhancing blood circulation; alleviating gastrointestinal stagnation; treating chronic diarrhea; and lowering blood sugar, cholesterol, triglycerides, etc. [10]. The natural pollination success rate of F. tataricum is relatively low, with the fruit set rate typically ranging between 15% and 35% [11,12]. In order to increase the yield of F. tataricum, people often apply fertilizer, with phosphate fertilizer being among the most utilized due to its capacity to enhance the filling degree and final yield of F. tataricum [13]. Typically, the phosphorus fertilizer applied in F. tataricum fields ranges from 45 kg/ha to 60 kg/ha [14,15]. However, the utilization rate during the season generally falls within a range from 10% to 25%. Unused phosphorus fertilizer can form insoluble phosphates with soil metal ions such as iron, aluminum, magnesium, and calcium in the soil [3,16,17]. Long-term and excessive use of phosphorus fertilizer can lead to phosphorus accumulation in the soil, resulting in the waste of non-renewable phosphorus mineral resources and environmental pollution [18]. Hence, exploring efficient phosphorus solubilization measures of green economy holds significant importance for addressing phosphorus deficiency in crops and non-point source pollution, maintaining ecological balance, etc.
Phosphate-solubilizing microorganisms (PSMs) have attracted much attention due to their ability to convert insoluble bound phosphorus into soluble free phosphorus that can be absorbed and utilized by plants, as well as their ability to interact with plants and regulate the effectiveness of plant rhizospheric phosphorus. Phosphate-solubilizing fungi, in particular, have emerged as a focal point for research due to their high phosphorus solubilization efficiency, strong adaptability, and high genetic stability [19]. It has been found that fungi generally have several times higher phosphorus solubilization ability than bacteria [20,21]. Furthermore, many bacteria lose their phosphorus solubilization ability during subculture, while fungi consistently maintain strong phosphorus solubilization activity and genetic characteristics [22,23,24]. Currently identified phosphate-solubilizing fungi include species such as Aspergillus niger [25], A. aculeatus [26] from the genus Aspergillus, Penicillium oxalicum [27], P. pinophilum [28] from the genus Penicillium [29,30,31], Fusarium oxysporum [32] from the genus Trichoderma [33,34], and Paecilomyces lilacinus [35] from the genus Paecilomyces [36,37].
I. cateniannulata, also known as Paecilomyces cateniannulatus or Cordyceps cateniannulata, belongs to the subphylum Entomophthoromycotina, class Zygomycetes, order Entomophthorales, and genus Cordyceps. It serves as an entomopathogenic fungus that is capable of controlling pests and diseases, while also promoting plant growth [38,39]. At present, it is found to enhance the growth of Tartary buckwheat seeds [38,40], tobacco [41,42], tomatoes [43], and other plants through endophytic colonization. However, it has not been reported whether its promotion of plant growth is related to its phosphorus-solubilizing ability.
Therefore, this study aimed to explore the phosphorus-dissolving ability of 18 strains of I. cateniannulata by analyzing their growth in an inorganic phosphate culture medium. Through field experiments, the influence of these strains on the growth of F. tataricum was assessed. The study is expected to provide the material and theoretical basis for the interaction mechanism of I. cateniannulata and F. tataricum and the research of I. cateniannulata as phosphate-solubilizing fungi.
2. Materials and Methods
2.1. Solid Medium Preparation and Determination of Phosphorus-Solubilization Index of Strains
Solid medium formulation: 10 g glucose, 0.5 g ammonium sulfate (Shanghai Aladdin Biochemical Technology Co., Shanghai, China), 0.3 g sodium chloride, 0.3 g potassium chloride (Tianjin Windship Chemical Reagent Technology Co., Tianjin, China), 0.03 g ferrous sulfate (Sinopharm Chemical Reagent Co., Shanghai, China), 0.5 g tricalcium phosphate (Chongqing Jiangchuan Chemical Co., Chongqing, China), 0.03 g manganese (II) sulfate tetrahydrate (Shanghai Eon Chemical Technology Co., Shanghai, China), 0.3 g zinc sulfate heptahydrate (Beijing Soleberg Technology Co., Beijing, China), 20 g Agar-agar. The solution was prepared by dissolving the mixture in 1000 mL of purified water [34]. The solution was transferred into 500 mL triangular flasks, with each flask not exceeding 300 mL. High-pressure sterilization was performed at 121 °C for 15 min. Afterward, the solution was transferred into culture dishes of 9 cm diameter, with each dish containing 25 of the medium. These dishes were then ready for use.
The strains of I. cateniannulata (Nos. 1–18, isolated from soil in buckwheat production area in Guizhou Province, China, currently preserved in the Research Center of Buckwheat Engineering and Technology, School of Life Sciences, Guizhou Normal University) were cultured on solid culture medium. After 15 days, a spore suspension with a concentration of 1 × 1010 spores/mL was prepared using sterile distilled water. Holes with a diameter of 0.2 cm were made in the center of the solid culture medium, and a volume of 10 μL of the spore suspension was inoculated into each circular hole, using a pipette gun (operated on super-clean worktable). The cultivation was conducted in an artificial climate box (manufactured by Ningbo Yanghui Instrument Co., Ltd., Ningbo, China) at a temperature of 25 °C, humidity of 70%, light intensity of 2000 lx, and light/dark cycle of 12:12. Observations and photographs were taken every 24 h. Measurements of colony diameter (D) and transparent zone diameter (d) were taken at multiple perpendicular directions on the 6th, 8th, and 10th days. The ratio of transparent zone diameter to colony diameter (D/d) was calculated as the phosphorus-solubilization index (PSI).
2.2. Preparation of Liquid Medium and Determination of Soluble Phosphorus Content of Strains
Liquid culture medium preparation: Agar powder was removed from 1.1 solid culture medium, and the remaining components were mixed in a 1000 mL beaker. Distilled water was added to reach a total volume of 1000 mL, and the mixture was dispensed into a 150 mL triangle bottle, with each flask containing 50 mL. The medium was then autoclaved at 121 °C for 15 min and allowed to cool below 25 °C. Next, 1 mL of fungal spore suspension with a concentration of 1 × 1010 spores/mL was added to each triangle bottle. The triangle bottle was cultivated continuously for 5 days at A temperature of 25 °C, humidity of 70%, light intensity of 2000 lx, and light/dark cycle of 12:12, with a rotation speed of 150 r/min. The pH of the medium was measured using a pH meter (Nanjing Sutest Instrument Co., Ltd., Nanjing, China) and then stored for future use.
Potassium phosphate monobasic (analytical reagent) (Chongqing Jiangchuan Chemical Co., Ltd., Chongqing, China) was accurately weighed to 0.4398 g, dried to constant weight, and then dissolved in distilled water to make a final volume of 1000 mL. The solution was mixed well, and 10 mL of this solution was taken and diluted to 100 mL with distilled water to prepare a 5 mg/L phosphate standard solution. Next, 0, 2, 4, 6, 8, 10, 12, and 14 mL of the phosphate standard solution were pipetted into separate 50 mL volumetric flasks. Dinitrophenol indicator (Shanghai Yien Chemical Technology Co., Ltd., Shanghai, China) was added (400 µL), followed by titration with 100 g/L sodium carbonate solution until the color of the solution just turned faint yellow. Then, 5 mL of molybdenum antimony color reagent (Xiamen Haibiao Technology Co., Ltd., Xiamen, China) was added, mixed well, and diluted to volume with distilled water. The solution was placed at room temperature above 15 °C for 30 min. The absorbance at a wavelength of 700 nm was measured using a UV–visible spectrophotometer (Beijing Puxi General Instrument Co., Ltd., Beijing, China), with absorbance as the y-axis and phosphate concentration as the x-axis, to plot the phosphate standard curve 1.
2.3. Determination of Phosphorus Solubilization Amount by I. cateinannulata
The molybdenum antimony colorimetric method [44] was used to determine the amount of phosphorus solubilization by I. cateinannulata strains: The 25 mL culture broth after 5 days of cultivation was centrifuged at 12,000 rpm for 5 min. Then, 4 mL of the supernatant was transferred to a 50 mL volumetric flask, followed by the addition of 26 mL of distilled water. Next, 400 µL of dinitrophenol indicator was added, and the solution was adjusted to a faint yellow color using a 100 g/L sodium hydroxide solution. Subsequently, 5 mL of molybdenum antimony color reagent was added, and the solution was shaken and diluted with distilled water to the mark. It was left to stand at a temperature above 15 °C for 30 min. The sterile liquid culture medium treated under the same conditions was used as a reference to adjust the zero point. The absorbance of the chromogenic solution was measured at a wavelength of 700 nm, using a UV–visible spectrophotometer, and the corresponding soluble phosphorus content was determined from the standard curve
2.4. Field Test Ring I. cateinannulata Strain on the Growth of F. tataricum
2.4.1. I. cateinannulata Roots Irrigation for F. tataricum
F. tataricum cultivation: From August to December 2023, small-scale experiments were conducted in the field (at the Experimental Base of Buckwheat Industry Technology Center, Guizhou Normal University, Anshun City, Guizhou Province, located at 106°7′7″ E, 26°5′9″ N, and an altitude of 1397 m). The experiments were conducted in plots with consistent water and fertilizer conditions. Variety rice F. tataricum 13 was selected as the experimental material. Each treatment was allocated to one plot, with each plot consisting of 3 rows and each row containing 80 plants. Each treatment was repeated 3 times, totaling 3 m2. A 1 m interval separated the experimental and control groups, and the management of the field was identical.
Rhizosphere inoculation experiment with I. cateinannulata: During the F. tataricum seedling stage (at 15 days of planting), spore suspensions of the strains exhibiting the highest phosphorous solubilizing capacity were selected for root irrigation. The irrigation was conducted for three consecutive days, with one application before sunrise and one application after sunset each day. The dosage for each application was 1.6 × 109 spores/m2, totaling 6 times.
2.4.2. Determination of Growth Index of F. tataricum
After 15 d, 30 d, and 80 d of root irrigation, the F. tataricum control group and experimental group were collected, with 10 plants per row and 30 plants per each treatment. They were then brought back to the laboratory to measure the plant height, stem diameter, number of branches, number of stems, length of the main root, and leaf area of F. tataricum.
2.4.3. Chlorophyll Determination
Fresh leaves of F. tataricum plants were taken, and the surface of the tissues were cleaned and cut into pieces (removing the midrib). Then, 0.1 g of the sample was weighed and placed into a 25 mL test tube. Subsequently, 15 mL of 95% ethanol was added to the test tube to completely immerse the sample in the ethanol solution. It was placed in darkness for 24 h to soak in order to turn into chlorophyll pigment extract. The extract was poured into a colorimetric cup, and 95% ethanol was used as a blank control. The absorbance was measured at wavelengths of 665 nm, 649 nm, and 470 nm [45]. The concentrations of chlorophyll a (Ca) and chlorophyll b (Cb) were calculated using the following formula (where A represents absorbance), as well as the content of each pigment per unit fresh weight in the tissue (unit mg/g):
Ca = 13.95 × A665 − 6.88 × A649
Cb = 24.96 × A649 − 7.32 × A665
The content of chloroplast pigments = (pigment concentration × extraction liquid volume)/sample fresh weight
2.4.4. Determination of Soluble Phosphorus Content in F. tataricum Plants
A total of 25 g of ammonium molybdate (provided by Chongqing Jiangchuan Chemical Co., Ltd., Chongqing, China) was weighed and dissolved in distilled water to make up a volume of 1000 mL to obtain a 2.5% ammonium molybdate solution. Then, 10 g of ascorbic acid (provided by Tianjin Zhiyuan Chemical Reagent Co., Ltd., Tianjin, China) was weighed and dissolved in 100 mL of distilled water to obtain a 10% ascorbic acid solution (due to its susceptibility to oxidation, it is prepared and used immediately). A mixture of distilled water, 6 mol/L phosphoric acid, 2.5% ammonium molybdate, and 10% ascorbic acid in a 2:1:1:1 volumetric ratio was prepared and stored in a brown bottle, serving as the phosphorus reagent (the liquid should not be used if it turns brown-yellow).
The phosphorus standard was prepared by taking 0, 0.2, 0.4, 0.6, 0.8, 1.0, and 1.4 mL from the 2.2 and placing them in 10 mL centrifuge tubes. To each tube, 3 mL of phosphorus reagent was added and made up to 6 mL with distilled water. The tubes were incubated in a 45 °C water bath for 25 min. The absorbance was measured at a wavelength of 660 nm, using an ELISA reader. The phosphorus standard curve 2 was plotted, with absorbance as the y-axis and phosphorus concentration as the x-axis.
Following the phosphomolybdenum blue colorimetric method [46], 0.1 g of fresh buckwheat roots, stems, leaves, and mature seeds was placed in a mortar. Then, 1.5 mL of distilled water was added separately, and the mixture was grinded into a homogenate and placed in a 2 mL centrifuge tube. The slurry was transferred to 2 mL centrifuge tubes and centrifuged at 6000 r/min for 15 min. From the supernatant, 0.2 mL was taken and mixed with 3 mL of phosphorus reagent. After dilution to 6 mL with distilled water and complete mixing, the tubes were incubated in a 45 °C water bath for 25 min. Afterward, 0.2 mL was taken to measure the absorbance at a wavelength of 660 nm [47]. The soluble phosphorus content in the samples was calculated based on the standard curve 2 (unit mg/g).
Sample solubility phosphorus content = Mx × V/V1 × W
In the formula: Mx is the phosphorus content (mg/L) in standard curve 2, V is the volume of sample extraction solution (mL), V1 is the volume of the sample used for measurement (mL), and W is the fresh weight of the sample (g).
2.5. Data Processing and Analysis
Excel 2022 was used for basic data statistical analysis and column chart/line chart creation of parameters such as the phosphorus index, phosphorus solubilization amount, and plant height. SPSS 24.0 or above was used for the statistical analysis of the data. The independent samples t-test method was applied to analyze the significant differences between the two groups of data at a significance level of 0.05. Tukey’s method was used to analyze the significant differences among multiple groups of data at a significance level of 0.05. Adobe Illustrator 2023 was used for image processing.
3. Results and Discussion
3.1. Analysis of Phosphorus-Solubilization Ability among Different Strains of I. cateinannulata
Based on observations over a period of 10 consecutive days, 17 strains of I. cateinannulata showed the formation of clear zones on solid culture medium (Figure 1c,d). As the strains grew, the clear zones gradually increased in size (Figure 1e,f), reaching their maximum size on the 10th day (Figure 1g,f). This increase occurs because phosphorus-solubilization fungi produce a large amount of organic acid substances during their growth process, such as oxalic acid, citric acid, glucose succinic acid, malic acid, acetic acid, and so on [48,49]. These substances can decompose calcium phosphate in the culture medium, resulting in the formation of a specific transparent zone around the fungal body. It is speculated that the growth of I. cateinannulata produces organic acid substances capable of decomposing calcium phosphate, but the specific types need further verification. The size of the transparent zone is mainly related to the phosphorus-solubilization index and phosphorus-solubilization ability of the phosphorus-dissolving fungus, and the phosphorus-solubilization index can be used as a preliminary indicator to characterize the phosphorus-solubilization ability of the phosphorus-solubilization fungus [50]. As shown in Table 1, the phosphorus-solubilization indices of the 17 fungal strains varied, consistent with Figure 1. These differences among different strains are influenced by the phosphate-solubilization ability, genetic characteristics, environmental factors, and so on [51]. On the 6th and 8th days, strain 2 had the highest phosphate-solubilizing index, which was significantly higher than that of other strains, except strain 2, 3, 6, 7, 11, and 17 (p < 0.05). On the 10th day, strain 7 had the highest pi; it was significantly higher than other strains, except 1 and 2 (p < 0.05). Strains 2, 6, 11, 14, and 18 showed a trend of initially increasing and then decreasing in terms of their phosphorus-solubilization index as time increased. These strains reached a maximum value on the 8th day, whereas, for the other strains, the phosphorus-solubilization index gradually increased to the maximum value on the 10th day. This occurs because certain phosphorus-solubilizing fungi preferentially utilize the solubilized phosphorus after decomposing the insoluble phosphorus [52], temporarily suspending or reducing the decomposition of insoluble phosphorus, resulting in an initial increase and subsequent decrease in the phosphorus-solubilization index. Additionally, it is possible that some strains have a single phosphorus-solubilization mechanism, while others have multiple mechanisms acting together, resulting in differences in their effectiveness [24,53]. The differences in phosphorus-solubilization ability among different strains of I. cateinannulata may be related to all of these reasons, which are currently under-validated. The plate “transparent zone” method is suitable only for the initial screening of phosphorus-solubilizing microorganisms due to its convenience and fast speed, but it lacks full reliability. Strain 15 did not exhibit a transparent zone (Figure 1a,b) and did not have a phosphorus-solubilization index (Table 1). Possible explanations include insufficient acidity produced by the strain, resulting in an in an unclear dissolution zone, or vigorous growth of the mycelium obscuring the small dissolution zone, among other reasons [54]. Further research is needed.
Figure 1.
The colony characteristics and transparent zone morphology of strain 15 and strain 9. (a) The front view of strain 15 on the 10th day shows the colony characteristics. (b) The back view of strain 15 on the 10th day shows the colony characteristics. (c) The front view of strain 9 on the 6th day shows the colony characteristics. (d) The back view of strain 9 on the 6th day shows the colony characteristics. (e) The front view of strain 9 on the 6th day shows the colony characteristics. (f) The back view of strain 9 on the 8th day shows the colony characteristics. (g) The front view of strain 9 on the 10th day shows the colony characteristics. (h) The back view of strain 9 on the 10th day shows the colony characteristics.
Table 1.
Phosphorus-solubilization index of 18 strains of Isaria cateinannulata.
Currently, the common methods for assessing the ability of phosphate-solubilizing fungi to solubilize phosphorus include a size measurement of the clear zone in a solid culture medium, the determination of the soluble phosphorus content in liquid culture medium, and an evaluation of available phosphorus content in soil–sand culture medium. Tian Xiang et al. screened a highly efficient phosphate-solubilizing strain using the phosphorus-solubilizing circle method and liquid culture method [55]; Sun Yaqin et al. obtained the FLP36 strain with high degradation ability for calcium phytate through the phosphorus-solubilizing circle method and liquid culture method [56]; and Lin Yuzha et al. evaluated the phosphorus-solubilizing ability of the P6 strain using three methods simultaneously [57]. In this study, the first two methods were employed to demonstrate, for the first time, the phosphorus-solubilizing capability of I. cateinannulata, with the observed phosphorus-solubilization range consistent with that of most phosphorus-releasing fungi [58,59].
3.2. Analysis of Soluble Phosphorus Content and pH in Different Strains of I. cateinannulata
The cultivation of the 18 strains of I. cateinannulata revealed a soluble phosphorus content ranging from 5.14 ± 0.37 mg/L to 6.21 ± 0.01 mg/L. Notable variations were observed among strains, with strain 9 and strain 4 demonstrating the highest and lowest soluble phosphorus content, respectively. Strain 9 was significantly higher than strains 4 and 11 (p < 0.05) (Figure 2a). This difference in phosphorus-solubilization ability among different strains can be attributed to variations in phosphorus mobilization mechanisms and efficiency. Despite not producing a transparent zone in solid culture medium, strain 15 exhibited a notable phosphorus-solubilization ability in the quantitative determination of soluble phosphorus content. This can be attributed to the strain’s enhanced ability to decompose and absorb phosphorus in the liquid culture system, potentially linked to the strain’s environmental adaptability [60]; however, the specific reasons remain to be explored. Figure 2b shows the standard curve, with a linear regression equation of y = 0.0916x + 0.0003 and an R2 value of 0.9992. The results indicate a strong linear correlation between the two variables.
Figure 2.
Phosphorus content and pH of 18 strains of Isaria cateinannulata. (a) Soluble phosphorus content (mg/L) in each bacterial solution after 5 days of cultivation. (b) Standard curve for measuring soluble phosphorus content in the bacterial solution. (c) pH value of each bacterial solution after 5 days of cultivation.
After 10 days of continuous cultivation, the pH of 18 strains of I. cateinannulata showed varying degrees of decline (Figure 2c). The pH ranged from 3.77 ± 0.20 to 4.75 ± 0.04. This is because 1/7 of the metabolites produced by I. cateinannulata are acidic organic compounds. Different strains secrete different types, amounts, and concentrations of organic acids during their growth, leading to different degrees of pH decline in the culture medium [61,62].
Variations in phosphorus-solubilizing ability among different strains of phosphorus-releasing fungi mainly stem from differences in their phosphorus release mechanisms. The Penicillium oxalicum y2 has been found to degrade phosphorus through phosphatase action without producing organic acids in the culture medium [63]. Conversely, strain HB1 of Penicillium oxalicum releases phosphorus through the secretion of H+ ions [33], while strain NJDL-03 solubilizes calcium phosphate by producing organic acids, mainly gluconic acid and oxalic acid [64]. In this study, differences in phosphorus-solubilizing ability among different strains of I. cateinannulata are attributed to the types and levels of organic acids secreted by the fungi. It has been found that I. cateinannulata secretes 93 kinds of acid substances, such as acetic acid and propionic acid, during the colonization process [38]. The large amounts of organic acids can lower the environmental pH, providing optimal conditions for phosphorus-releasing fungi to release phosphorus [65]. This acidic environment facilitates the conversion of insoluble phosphate into plant-utilizable free phosphate [66]. Lin Qimei et al. reported that phosphorus-solubilizing fungi maintain the pH of the fungal broth at around 3.0 during their growth and reproduction by producing organic acids and protons, leading to the structural destruction of phosphate rocks [67]. In this study, the pH of I. cateinannulata was slightly higher than that of other phosphorus-solubilizing fungi [66], which may be related to the concentration, types, and content of the secreted organic acids [68,69].
3.3. The Effect of I. cateinannulata on the Soluble Phosphorus Content in F. tataricum Plants
The application of I. cateinannulata irrigation can significantly increase the soluble phosphorus content in the roots, stems, and leaves of F. tataricum seedlings during the seedling stage (p < 0.05). These increases are 1.38 times, 1.15 times, and 1.28 times higher compared to the control group, as shown in Figure 3a. This is because phosphate-solubilizing fungi increase the soluble phosphorus content in the soil through various phosphorus-solubilizing mechanisms, such as organic acid secretion and phosphatase production, thus facilitating the absorption of soluble phosphorus by crops and promoting the growth of seedling roots and stems [67,70,71].
Figure 3.
The effect of Isaria cateinannulata inoculation on the soluble phosphorus content of different stages of Fagopyrum tataricum under ring-chain rod bundle spore irrigation in the CK (control group) and experimental group (the treatment group after I. cateinannulata root irrigation). (a) The soluble phosphorus content (mg/g) in various parts of Fagopyrum tataricum during the seedling stage (15 days after root irrigation); (b) the soluble phosphorus content (mg/g) in various parts of Fagopyrum tataricum during the filling stage (30 days after root irrigation); (c) the soluble phosphorus content (mg/g) in various parts of Fagopyrum tataricum during the mature stage (80 days after root irrigation); and (d) the standard curve for measuring the soluble phosphorus content in different parts of Fagopyrum tataricum. ‘*’ indicates that the difference between the experimental group and the control group is significant, and ‘**’ indicates that the difference between the experimental group and the control group is extremely significant.
During the filling stages, the load on the stems of I. cateinannulata increases, and phosphorus can increase stem toughness and improve lodging resistance. At this time, the transport capacity of phosphorus is much greater than in other periods. At the same time, I. cateinannulata undergoes blooming and fruiting, requiring phosphorus for tillering and earing promotion. In this study, the soluble phosphorus content and total soluble phosphorus content in the roots, stems, and leaves of bitter buckwheat during the grouting period were significantly higher than those in the control group (p < 0.05), with increases of 1.38 times, 1.91 times, 1.27 times, and 1.33 times, respectively (Figure 3b). This indicates that the use of I. cateinannulata can increase the phosphorus content in F. tataricum during the tillering period, ensuring a balanced nutrient status and fulfilling plant-growth requirements.
The soluble phosphorus content in the seeds during the filling stages showed no significant difference compared to the control group (p > 0.05), as depicted in Figure 3b. This phenomenon arises from the predominant focus of F. tataricum growth and development on the seed maturation during the tillering period. Phosphorus plays a role in coordinating the source–sink relationship in plants, promoting the translocation of photosynthetic products to the grains [72], thereby increasing grain number and weight [73]. Consequently, phosphorus did not accumulate in large quantities in the seeds during the tillering period, as shown in Figure 3b. The soluble phosphorus content of mature F. tataricum seeds (at 80 days after roots irrigation) was significantly higher than that of the control group (p < 0.05), at 238.64 ± 1.84 mg/g; thus, it is 1.42 times higher than that of the control group (Figure 3c). This elevation stems from the diminished need for phosphorus in coordinating growth and development after seed maturation, resulting in its accumulation in the seeds and a significantly higher phosphorus content in the experimental group relative to the control group. The standard curve in Figure 3d follows a linear regression equation of y = 0.2702 + 0.0312, with an R2 value of 0.9984. The results indicate a strong linear correlation between the two variables.
Phosphate-solubilizing fungi enhance the conversion of available phosphorus in the soil, increasing the soluble phosphorus content in crops and thereby boosting crop growth and productivity. These fungi secrete organic acids that activate insoluble phosphorus in the soil, increasing the content of available phosphorus [74]. PSWY, a phosphate-solubilizing fungi, improves the available phosphorus content in the soil, promotes the development of pepper roots, increases aboveground dry weight, and significantly enhances yield [75]. Similarly, the phosphate-solubilizing fungi G17 and WJ27 promote the growth of Masson pine by increasing soil nutrients and the content of P, N, and K in seedlings [76]. In this study, I. cateinannulata produced a large amount of fine mycelium in the soil, reaching areas beyond the reach of root growth, expanding the root surface area, and increasing the rhizosphere coverage [77,78]. This allowed plant roots to access previously unavailable phosphorus, which was subsequently decomposed and made available for plant absorption, thereby increasing the soluble phosphorus content in crops.
3.4. Effect of Rhizosphere Irrigation with I. cateinannulata on Chlorophyll Content of F. tataricum
I. cateinannulata irrigation significantly increased the content of chlorophyll a, chlorophyll b, and total chlorophyll in the seedling stage of F. tataricum compared to the control group (p < 0.05). The respective values were 777.01 ± 9.99 mg/g, 707.54 ± 13.64 mg/g, and 1470.48 ± 21.76 mg/g, which were 1.10 times, 1.61 times, and 1.58 times higher than the control group (Figure 4a). This can be attributed to the increase in phosphorus content in F. tataricum induced by the I. cateinannulata increase, where the surplus phosphorus accelerated the synthesis of substances such as DNA, RNA, ATP, etc. [79,80]. Consequently, this leads to chlorophyll accumulation and an augmentation in the chlorophyll content within the seedling leaves. In contrast, there is no significant difference in the content of chlorophyll a, chlorophyll b, and total chlorophyll in the grain filling stage of F. tataricum compared to the control group (p > 0.05) (Figure 4b). This observation could be attributed to the increase in soil-available phosphorus concentration over time, inducing a state of high phosphorus level in the plants. Moreover, thickening or yellowing of leaves can inhibit chlorophyll synthesis and reduce the rate of chlorophyll synthesis [81].
Figure 4.
The effect of Isaria cateinannulata root irrigation on the chlorophyll content of Fagopyrum tataricum leaves at different stages. (a) Chlorophyll content in leaves of Fagopyrum tataricum seedlings (15 days after root irrigation) is measured in mg/g. (b) Chlorophyll content in leaves of Fagopyrum tataricum during the filling stage (30 days after root irrigation) is measured in mg/g. ‘*’ indicates that the difference between the experimental group and the control group is significant, and ‘**’ indicates that the difference between the experimental group and the control group is extremely significant.
Phosphate-solubilizing fungi influence the chlorophyll content of crops by increasing the available phosphorus. These fungi elevate crop phosphorus levels, promote the synthesis of ATP and NADPH, and enhance chlorophyll content in Chinese fir seedlings, thus facilitating plant growth [82]. Additionally, Song Wenchao et al. observed that phosphorus in the soil can cause fluctuations in chlorophyll-a production in red-leaf grass, thereby increasing the chlorophyll content [83]. In this study, the I. cateinannulata was found to enhance the chlorophyll content of F. tataricum leaves, possibly through gene expression involved in photosynthetic pathways [84], and it also increased the nitrogen and phosphorus content in the leaves [85]. However, further research is needed to elucidate the underlying mechanisms.
3.5. The Effect of I. cateinannulata on the Growth of F. tataricum at Different Stages
After root irrigation with I. cateinannulata, the stem diameter, stem node number, branch number, and leaf area of F. tataricum at the seedling stage (Figure 5a), filling stage (Figure 5b), and mature stage (Figure 5c) were not significantly different from those of the control group (p > 0.05). However, the plant height of F. tataricum was significantly higher than that of the control group, i.e., 1.17 times, 1.07 times, and 1.09 times higher than the control group, respectively (p < 0.05) (Table 2). This phenomenon can be attributed to the promotion of F. tataricum growth via root irrigation with I. cateinannulata [38,40]. Additionally, the main root length in the experimental group significantly surpassed that in the control group, being 1.24 times, 1.30 times, and 1.18 times higher than the control group, respectively (p < 0.05) (Table 2). This result correlated with the available phosphorus content in the environment. When plants are grown in an environment with sufficient phosphorus, it can promote the elongation of main root cells [86,87], and vice versa. The ability of roots to absorb phosphorus is a major limiting factor in plant growth, and factors such as root morphology, physiology, biochemistry, and symbiotic characteristics are related to the efficiency of plant phosphorus absorption. This indirectly indicates that I. cateinannulata can promote an increase in the concentration of available phosphorus in the soil; induce main root cell division, proliferation, and elongation; enhance the absorption capacity of F. tataricum roots for available phosphorus; and increase plant height.
Figure 5.
The Fagopyrum tataricum and yield at different stages of roots irrigation with Isaria cateinannulata. (a) Seedling-stage Fagopyrum tataricum. (b) Control-group Fagopyrum tataricum in the filling stage. (c) Experimental-group Fagopyrum tataricum in the filling stage. (d) Control-group Fagopyrum tataricum in the mature stage. (e) Experimental-group Fagopyrum tataricum in the mature stage. (f) Control-group and experimental-group 1 m2 yield.
Table 2.
The effects of root irrigation with Isaria cateinannulata at different stages on the growth of Fagopyrum tataricum.
The seed filling and final yield [88,89] typically correlate with the crop-available phosphorus content. Phosphorus deficiency during the growth stage may cause a metabolic imbalance and an abnormal accumulation of dry matter, inhibiting protein synthesis [88]. In this study, the seed yield per square meter at the maturity stage of F. tataricum (Figure 5f) in the experimental group was 2.26 times higher than that of the control group (Table 2). This is due to the fact that I. cateinannulata can enhance the absorption of soluble phosphorus by F. tataricum, and sufficient phosphorus can promote tillering, spike production, and yield increase. However, the specific mechanism still needs further investigation.
4. Conclusions
This study is the first to demonstrate the phosphate-solubilizing ability of I. cateinannulata, with phosphorus solubilization ranging from 6.21 ± 0.01 mg/L to 5.14 ± 0.37 mg/L. I. cateinannulata promotes F. tataricum growth and yield by lowering environmental pH and increasing chlorophyll and soluble phosphate content in leaves. This research provides a material and theoretical basis for developing I. cateinannulata as a phosphate-solubilizing fungal fertilizer and investigating its phosphate-solubilizing mechanism.
Author Contributions
G.Y. conceived and designed the experiments and wrote the manuscript; C.L. carried out the review and editing; L.G. analyzed data and drafted the manuscript; X.Z. contributed project administration and funding acquisition; Q.C. contributed the supervision. All authors have read and agreed to the published version of the manuscript.
Funding
This study was supported by the Key Science and Technology Projects in Yunnan (202202AE090020) and the Earmarked Fund for China Agriculture Research System (CARS-07-A5).
Institutional Review Board Statement
Not applicable.
Informed Consent Statement
Not applicable.
Data Availability Statement
The data that support the findings of this study are available from the corresponding author and the first author upon reasonable request.
Conflicts of Interest
The authors declare no conflict of interest.
References
- Liu, X.; Guo, X.; Chen, Y.; Fan, C.; Hu, Z.; Zhang, X. Response Strategies and Molecular Mechanisms of Phosphate Deficiency in Plants. Mol. Plant Breed. 2023, 1–12. Available online: https://link.cnki.net/urlid/46.1068.S.20230906.1318.002 (accessed on 17 March 2024).
- Shenoy, V.V.; Kalagudi, G.M. Enhancing plant phosphorus use efficiency for sustainable cropping. Biotechnol. Adv. 2005, 23, 501–513. [Google Scholar] [CrossRef]
- Soumare, A.; Boubekri, K.; Lyamlouli, K.; Hafidi, M.; Ouhdouch, Y.; Kouisni, L. From isolation of phosphate solubilizing microbes to their formulation and use as biofertilizers: Status and needs. Front. Bioeng. Biotechnol. 2020, 7, 425. [Google Scholar] [CrossRef]
- de Barros Mesquita, C.; Garcia, É.L.; Bolfarini, A.C.B.; Leonel, S.; Franco, C.M.L.; Leonel, M. Phosphate fertilization changes the characteristics of ‘Maçã’ banana starch. Int. J. Biol. Macromol. 2018, 112, 1138–1145. [Google Scholar] [CrossRef]
- Suzuki, Y.; Ishiyama, K.; Yoon, D.K.; Takegahara-Tamakawa, Y.; Kondo, E.; Suganami, M.; Makino, A. Suppression of chloroplast triose phosphate isomerase evokes inorganic phosphate-limited photosynthesis in rice. Plant Physiol. 2022, 188, 1550–1562. [Google Scholar] [CrossRef]
- CY, K.; SF, F.; Chou, F.C.; Chen, R.Y.; Chou, J.Y. Phosphate-solubilizing characteristics of yeasts. Mycosphere 2018, 9, 1117–1131. [Google Scholar]
- Yang, Q.; Han, J.; Li, Y.; Xiao, K.; Liu, Y. Effects of different phosphorus levels on leaf photosynthetic performance and yield traits of wheat. J. Plant Nutr. Fertil. 2006, 12, 816–821. [Google Scholar]
- Wang, X. Effects of Phosphorus on Yield and Quality of Wheat and Its Physiological Basis. Ph.D. Thesis, Shandong Agricultural University, Taian, China, 2003. [Google Scholar]
- Tao, P. Study on the Photosynthetic Characteristics and Leaf Proteomics of Maize under Low Phosphorus Stress. Ph.D. Thesis, Shandong University, Taian, China, 2009. [Google Scholar]
- Luthar, Z.; Golob, A.; Germ, M.; Vombergar, B.; Kreft, I. Tartary buckwheat in human nutrition. Plants 2021, 10, 700. [Google Scholar] [CrossRef]
- Xiang, D.B.; Song, Y.; Song, C.; Wan, Y.; Ye, X.L.; Liu, C.Y.; Zhao, G. Seed Setting and Its Spatial Characteristics in Tartary Buckwheat (Fagopyrum tataricum). Phyton 2022, 91, 1659–1669. [Google Scholar] [CrossRef]
- Song, Y. Fruitful Characteristics of Different Varieties of Bitter Buckwheat and Their Response to Source-Sink Regulation. Ph.D. Thesis, Chengdu University, Chengdu, China, 2019. [Google Scholar]
- Li, Z.; Wang, Y.; Wu, X.; Zhou, L.; Li, Z.; Huang, K. Effects of phosphorus fertilizer treatment on filling characteristics and solidification of bitter buckwheat. Shanghai J. Agric. Sci. 2020, 36, 29–34. [Google Scholar]
- Liu, S.; Li, X. High-yield cultivation techniques of bitter buckwheat. Nong Jia Can Mou 2021, 48–50. [Google Scholar]
- Wang, X. Mechanism of Fertilizer and Exogenous Hormone Regulation on Filling and Yield Formation in Thin-Shelled Bitter Buckwheat. Ph.D. Thesis, Guizhou Normal University, Guiyang, China, 2023. [Google Scholar]
- Qarni, A.; Billah, M.; Hussain, K.; Shah, S.H.; Ahmed, W.; Alam, S.; Khan, N. Isolation and characterization of phosphate solubilizing microbes from rock phosphate mines and their potential effect for sustainable agriculture. Sustainability 2021, 13, 2151. [Google Scholar] [CrossRef]
- Barrow, N.J. The effects of pH on phosphate uptake from the soil. Plant Soil 2017, 410, 401–410. [Google Scholar] [CrossRef]
- Xie, J.; Yan, Z.; Chen, D. A bacterium isolated from soil in a karst rocky desertification region has efficient phosphate-solubilizing and plant growth-promoting ability. Front. Microbiol. 2021, 11, 625450. [Google Scholar] [CrossRef]
- Rashid, M.; Khalil, S.; Ayub, N.; Alam, S.; Latif, F. Organic acids production and phosphate solubilization by phosphate solubilizing microorganisms (PSM) under in vitro conditions. Pak. J. Biol. Sci. 2004, 7, 187–196. [Google Scholar] [CrossRef]
- Kucey, R.M.N.; Janzen, H.H.; Leggett, M.E. Microbially mediated increases in plant-available phosphorus. Adv. Agron. 1989, 42, 199–228. [Google Scholar]
- Lin, Q.; Wang, H.; Zhao, X.; Zhao, Z. Preliminary investigation on phosphatases activity and mechanism of some bacteria and fungi. Microbiol. Bull. 2001, 26–30. [Google Scholar] [CrossRef]
- Yang, L.; Guo, L.; Zhou, Y.; Wang, J.; Liang, C.; Xu, Y.; Huang, J. Screening and phosphate-solubilizing activity evaluation of multifunctional phosphate-solubilizing fungi. J. Trop. Crops 2023, 44, 1662–1670. [Google Scholar]
- Yu, H.; Zhou, F.; Li, F.; Zhang, G.; Zhou, H.; Zhang, X. Research progress on phosphate-solubilizing microorganisms and their application in soil pollution prevention and control. Environ. Sci. Technol. 2020, 43, 44–51. [Google Scholar]
- Qiao, H.; Sun, X.R.; Wu, X.Q.; Li, G.E.; Wang, Z.; Li, D.W. The phosphate-solubilizing ability of Penicillium guanacastense and its effects on the growth of Pinus massoniana in phosphate-limiting conditions. Biol. Open 2019, 8, bio046797. [Google Scholar]
- Kaur, G.; Reddy, M.S. Improvement of crop yield by phosphate-solubilizing Aspergillus species in organic farming. Arch. Agron. Soil Sci. 2017, 63, 24–34. [Google Scholar] [CrossRef]
- Maharana, R.; Das, S.; Dhal, N.K.; Dinda, S.; Singh, B.M. Characterization and Mechanisms of Biosolubilization of Rock Phosphate by Microbes Isolated from Mahanadi Estuary, Odisha, India. Int. J. Environ. Res. 2021, 15, 335–348. [Google Scholar] [CrossRef]
- Wang, Y.Y.; Li, P.S.; Zhang, B.X.; Wang, Y.P.; Meng, J.; Gao, Y.F.; Hu, X.M. Identification of phosphate-solubilizing microorganisms and determination of their phosphate-solubilizing activity and growth-promoting capability. BioResources 2020, 15, 2560–2578. [Google Scholar] [CrossRef]
- Majumder, M.S.I.; Islam, M.K.; Akamine, H.; Sano, A.; Onjo, M.; Hossain, M.A. Comparative study of phosphate solubilization potential of Talaromyces pinophilus strains. Appl. Ecol. Environ. Res. 2019, 17, 14973–14984. [Google Scholar] [CrossRef]
- Coutinho, F.P.; Felix, W.P.; Yano-Melo, A.M. Solubilization of phosphates in vitro by Aspergillus spp. and Penicillium spp. Ecol. Eng. 2012, 42, 85–89. [Google Scholar] [CrossRef]
- Khan, M.S.; Zaidi, A.; Ahmad, E. Mechanism of phosphate solubilization and physiological functions of phosphate-solubilizing microorganisms. In Phosphate Solubilizing Microorganisms: Principles and Application of Microphos Technology; Springer: Berlin/Heidelberg, Germany, 2014; pp. 31–62. [Google Scholar]
- Ram, H.; Malik, S.S.; Dhaliwal, S.S.; Kumar, B.; Singh, Y. Growth and productivity of wheat affected by phosphorus-solubilizing fungi and phosphorus levels. Plant Soil Environ. 2015, 61, 122–126. [Google Scholar] [CrossRef]
- Bektas, I.; Kusek, M. Biological control of onion basal rot disease using phosphate solubilising rhizobacteria. Biocontrol Sci. Technol. 2021, 31, 190–205. [Google Scholar] [CrossRef]
- Li, Z.; Bai, T.; Dai, L.; Wang, F.; Tao, J.; Meng, S.; Hu, S. A study of organic acid production in contrasts between two phosphate solubilizing fungi: Penicillium oxalicum and Aspergillus niger. Sci. Rep. 2016, 6, 25313. [Google Scholar] [CrossRef]
- Yang, R.; Wang, J.; Xu, S.; Zhao, W.; Liu, H.; Li, Q.; Huang, Z. Screening of phosphate solubilizing fungi and analysis of their salt tolerance characteristics. Microbiol. Bull. 2018, 45, 2142–2151. [Google Scholar]
- Wang, X.L.; Qiu, S.Y.; Zhou, S.Q.; Xu, Z.H.; Liu, X.T. Phosphate-Solubilizing Capacity of Paecilomyces lilacinus PSF7 and Optimization Using Response Surface Methodology. Microorganisms 2023, 11, 454. [Google Scholar] [CrossRef]
- Erkfeldt, S. Slow and steady phosphate solubilization by a psychrotolerant strain of Paecilomyces hepiali (MTCC9621). World J. Microbiol. Biotechnol. 2011, 27, 1055–1062. [Google Scholar]
- Hernández-Leal, T.I.; Carrión, G.; Heredia, G. In vitro phosphate solubilization by a strain of Paecilomyces lilacinus (Thom) Samson. Agrociencia. 2011, 45, 881–892. [Google Scholar]
- Peng, X. The Influence of the Dynamic Colonization of Nematodospora coryli on Enzyme Activity and Metabolic Products during Buckwheat Seed Germination. Ph.D. Thesis, Guizhou Normal University, Guiyang, China, 2023. [Google Scholar]
- Liang, Z. Two new species of Aspergillus. Acta Microbiol. Sin. 1981, 21, 31–34+132. [Google Scholar]
- Zhang, X.; Peng, X.; Yang, G.; Chen, Q.; Jin, D. The colonization and effect of Isaria cateinannulata on buckwheat sprouts. Plants 2022, 12, 145. [Google Scholar]
- Qiao, L.; Liu, J.; Zhou, Z.; Li, Z.; Zhou, Y.; Xu, S.; Zou, X. Positive effects of Cordyceps cateniannulata colonization in tobacco: Growth promotion and resistance to abiotic stress. Front. Microbiol. 2023, 14, 1131184. [Google Scholar] [CrossRef]
- Xu, S. The Influence of Nematodospora coryli Colonization on Tobacco Growth and Rhizosphere Microbial Diversity. Ph.D. Thesis, Guizhou University, Guiyang, China, 2021. [Google Scholar]
- Guan, J. Construction of Nematodospora coryli and Tomato Symbionts and Their Effects on Tetranychus urticae. Ph.D. Thesis, Guizhou University, Guiyang, China, 2022. [Google Scholar]
- Zhang, L.; Zhang, G.; Wang, X.; Du, A.; Li, J.; Chang, Y.; Xu, N. Screening of Strains for Organophosphorus-degradation in Soil. J. Shandong Agric. Univ. 2019, 50, 774–777. [Google Scholar]
- Arnen, D.I. Copper enzymes in isolated chloroplasts: Polyphenol oxidase in Beta dulgaris. Plant Physiol. 1949, 24, 1–15. [Google Scholar] [CrossRef]
- Liu, R.; Zhang, J.; Jiang, T. Study on the content of phytic acid in winter and spring wheat bran in Xinjiang. J. Urumqi Adult Educ. Inst. 1997, 1, 55–58. [Google Scholar]
- Hu, X.; Wu, Q.; Huang, B.; Yan, Z.; Tang, X.; Dong, Q. Determination of phospholipid in different germplasm of Polygonummultiflorum by molybdenum blue colorimetry. Pop. Technol. 2014, 16, 92–94. [Google Scholar]
- Rfaki, A.; Zennouhi, O.; Aliyat, F.Z.; Nassiri, L.; Ibijbijen, J. Isolation, selection and characterization of root-associated rock phosphate solubilizing bacteria in moroccan wheat (Triticum aestivum L.). Geomicrobiol. J. 2020, 37, 230–241. [Google Scholar] [CrossRef]
- Wan, W.; Qin, Y.; Wu, H.; Zuo, W.; He, H.; Tan, J.; He, D. Isolation and characterization of phosphorus solubilizing bacteria with multiple phosphorus sources utilizing capability and their potential for lead immobilization in soil. Front. Microbiol. 2020, 11, 510229. [Google Scholar] [CrossRef]
- Sun, Q.; He, Z.; Ouyang, J.; Zhang, P.; Ji, X.; Chen, Y.; He, G. Composition and phosphorus solubilization ability of rhizosphere phosphate solubilizing bacteria in wild chestnut. Agric. Sci. Technol. 2023, 24, 56–64. (In English) [Google Scholar]
- Zhu, F.; Qu, L.; Hong, X.; Sun, X. Isolation and Characterization of a Phosphate-Solubilizing Halophilic Bacterium Kushneria sp. YCWA18 from Daqiao Saltern on the Coast of Yellow Sea of China. Evid.-Based Complement. Altern. Med. 2011, 2011, 615032. [Google Scholar] [CrossRef]
- Kin, K.Y.; Mcdonald, G.A.; Jordan, D. Solubilization of hydroxyapatite by Enterobacter agglomerans and cloned Escherichia coli in culture medium. Biol. Fertil. Soils 1997, 24, 347–352. [Google Scholar]
- Li, X.; Liu, C.; Zhao, H.; Gao, F.; Ji, G.; Hu, F.; Li, H. Similar positive effects of beneficial bacteria, nematodes and earthworms on soil quality and productivity. Appl. Soil Ecol. 2018, 130, 202–208. [Google Scholar]
- Ye, J.; Wei, X.; Guo, M.; Jiang, Y.; Dai, J. Preliminary screening of a phosphorus-solubilizing bacterium that does not produce “transparent zone” and its preliminary determination of phosphorus-solubilizing ability. Anhui Agric. Sci. Bull. 2016, 22, 38–39. [Google Scholar]
- Tian, X.; Han, X.; Huang, P.; Li, W.; Yang, Q.; Yang, M. Study on phosphate-solubilizing ability of a high efficiency phosphate-solubilizing bacterium in rhizosphere of Parashorea chinensis Wang Hsie. J. Hubei Agric. Sci. 2023, 62, 51–56. [Google Scholar]
- Sun, Y.; Ye, S.; Fan, G.; Zhang, Y.; Liu, X.; Wu, D.; Wang, F. Screening of Phosphate-solubilizing Bacteria in Wheat Field Soil and Its Phosphate-solubilizing Ability. Appl. Acta Agric. Boreali-Occi-Dent. Sin. 2022, 31, 379–387. [Google Scholar]
- Lin, Y.; Liu, J.; Lu, H.; Ding, Y.; Yan, L. Screening phosphate-solubilizing fungi from the mangrove rhizosphere and their effect on Aegiceras corniculatum seedling growth. J. Agro-Environ. Sci. 2022, 41, 950–958. [Google Scholar]
- Jiang, H.; Zhang, J.; Liang, Y.; Fan, Y.; He, H. Isolation and identification of phosphate-solubilizing fungi and analysis of their phosphate-solubilizing ability. Mod. Agric. Sci. Technol. 2024, 170–172. [Google Scholar] [CrossRef]
- Jiang, H.; Qi, P.; Wang, T.; Chen, M.; Chi, X.; Wang, M.; Chen, N.; Pan, L. Isolation, Identification and Biological Identification of Phosphate-solubilizing Fungi (PSF). China Soil Agric. 2018, 49, 856–861. [Google Scholar]
- Li, X.; Zhang, D.; Zhao, F.; Jiang, Y.; Zeng, X.; Wang, X.; Cheng, L. Screening and Analysis of Two Strains of High Efficiency Phosphor-Soluble Bacteria. J. Microbiol. 1–10. Available online: http://kns.cnki.net/kcms/detail/21.1186.Q.20231116.1438.004.html (accessed on 17 March 2024).
- Liu, Z.; Li, Y.C.; Zhang, S.; Fu, Y.; Fan, X.; Patel, J.S.; Zhang, M. Characterization of phosphate-solubilizing bacteria isolated from calcareous soils. Appl. Soil Ecol. 2015, 96, 217–224. [Google Scholar] [CrossRef]
- Yang, T.; Li, L.; Shi, F. Isolation, mutagenesis, and organic acid secretion of a highly efficient Phosphate-solubilizing fungus. Front. Microbiol. 2022, 13, 793122. [Google Scholar] [CrossRef]
- Wang, J.; Zhao, Y.G.; Maqbool, F. Capability of Penicillium oxalicum y2 to release phosphate from different insoluble phosphorus sources and soil. Folia Microbiol. 2020, 66, 69–77. [Google Scholar] [CrossRef]
- He, D.; Geng, L.; Guo, J.; Lu, X.; Liu, W.; Li, B. Ability and mechanism of Penicillium oxalicum HB1solubilizing phosphates. Trans. Chin. Soc. Agric. Eng. (Trans. CSAE) 2020, 36, 255–265. [Google Scholar]
- Tian, D.; Wang, W.; Su, M.; Zheng, J.; Wu, Y.; Wang, S.; Hu, S. Remediation of lead-contaminated water by geological fluorapatite and fungus Penicillium oxalicum. Environ. Sci. Poll. 2018, 25, 21118–21126. [Google Scholar] [CrossRef]
- Rodrogues, K.; Rodrogues, B. Development of carrier based in vitro produced arbuscular mycorrhizal (AM) fungal inocula for organic agriculture. Ann. Adv. Agric. Sciences. 2017, 18, 471–483. [Google Scholar]
- Ling, Q.; Zhao, H.; Zhao, X. The Characteristics of dolubilizing rock phosphate by four isolates of bacteria and fungi. Microbiology 2002, 24–28. [Google Scholar] [CrossRef]
- Wang, W. Screening of Phosphorus-Solubilizing Fungus and Analysis of Its Phosphorus-Solubilizing Mechanism. J Trop. Agric. Sci. 2018, 38, 64–67. [Google Scholar]
- Qiao, X.; Wu, Z.; Wang, X. Phosphate-solubilizing characteristic of a Penicillium pinophilum strain JP-NJ4. Microbiol. Bull. 2014, 41, 1741–1748. [Google Scholar]
- LI, T.; Fu, Z.; LI, X. Effects of Inoculation of Arbuscular Mycorrhizal Fungi and Phosphate-solubilizing Bacteria on Maize Growth and Phosphorous Nutrient Uptake in Low Phosphorous Field. Chin. J. Soil Sci. 2017, 48, 922–929. [Google Scholar]
- Yadav, R.S.; Tarafdar, J.C. Phytase and phosphatase producing fungi in arid and semi-arid soils and their efficiency in hydrolyzing different organic P compounds. Soil Biol. Biochem. 2003, 35, 745–751. [Google Scholar] [CrossRef]
- Zhan, X.; Han, X.; Yang, J.; Liu, X.; Ma, L. Effects of different nitrogen, phosphorus and potassium application rates on the dynamic changes of dry matter accumulation in maize source and sink. Soil Bulletin. 2007, 495–499. [Google Scholar] [CrossRef]
- Geng, X.; Wu, H.; Fu, P.; Liu, G.; Gao, Z. Effect of Phosphate Fertilizer on Seed and Hay Yield of Avena sativa in Linxia of Gansu Province. Acta Agrestia Sin. 2023, 31, 813–818. [Google Scholar]
- Li, D.; Shuang, H.; Wei, F.; Na, N.; Yan, L. Screening, identification, and phosphate solubilizing characteristics of a new efficient phosphate solubilizing fungus. Chin. J. Appl. Ecol. 2019, 30, 2384–2392. [Google Scholar]
- Wu, H.; Yu, M.; Feng, J.; Liu, H. Effect of Phosphorus Solubilizing Bio-fertilizer on Soil Phosphorus Availability and Pepper Yield in Greenhouse. J. Agric. Sci. Technol. 2023, 25, 189–197. [Google Scholar]
- Xu, H.; Lv, J.; Yu, C. Combined phosphate-solubilizing microorganisms jointly promote Pinus massoniana growth by modulating rhizosphere environment and key biological pathways in seedlings. Ind. Crops Products. 2023, 191, 116005. [Google Scholar] [CrossRef]
- Johansson, J.F.; Paul, L.R.; Finlay, R.D. Microbial interactions in the mycorrhizosphere and their significance for sustainable agriculture. FEMS Microbiol. Ecol. 2004, 48, 1–13. [Google Scholar] [CrossRef]
- Wooley, S.C.; Paine, T.D. Infection by mycorrhizal fungi increases natural enemy abundance on tobacco (Nicotiana rustica). Environ. Entomol. 2011, 40, 36–41. [Google Scholar] [CrossRef]
- Zhao, X.; Deng, Y.; Chen, S.; Zhang, B. Effects of Nitrogen Combined with Phosphate Applying on Yield and Water and Fertilizer Use Efficiency of Tatary Buckwheat in Dryland. J. North China Agric. Sci. 2016, 31, 350–355. [Google Scholar]
- Cruz-Ramírez, A.; Oropeza-Aburto, A.; Razo-Hernández, F.; Ramírez-Chávez, E.; Herrera-Estrella, L. Phospholipase DZ2 plays an important role in extraplastidic galactolipid biosynthesis and phosphate recycling in Arabidopsis roots. Proc. Natl. Acad. Sci. USA 2006, 103, 6765–6770. [Google Scholar] [CrossRef]
- Buchanan, B.B.; Gruissem, W.; Jones, R.L. (Eds.) Biochemistry and Molecular Biology of Plants; John Wiley & Sons: Hoboken, NJ, USA, 2015. [Google Scholar]
- Yang, S.; Yu, W.; He, Y.; Zhu, Q.; Wu, C.; Lin, H.; Li, J. Effects of three phosphate-solubilizing bacteria on photosynthetic physiological characteristics of Chinese fir seedlings. J. Xiamen Univ. (Nat. Sci. ) 2023, 62, 865–872. [Google Scholar]
- Song, W.; Gong, S.; Wu, Y. Effects of N, P, K fertilizers on pigment content of Coleus blumei. Mod. Hortic. 2012, 6. [Google Scholar] [CrossRef]
- Koczorski, P.; Furtado, B.U.; Baum, C.; Weih, M.; Ingvarsson, P.; Hulisz, P.; Hrynkiewicz, K. Large effect of phosphate-solubilizing bacteria on the growth and gene expression of Salix spp. at low phosphorus levels. Front. Plant Sci. 2023, 14, 1218617. [Google Scholar] [CrossRef]
- Wu, F.; Li, J.; Chen, Y.; Zhang, L.; Zhang, Y.; Wang, S.; Liang, J. Effects of phosphate solubilizing bacteria on the growth, photosynthesis, and nutrient uptake of Camellia oleifera Abel. Forests 2019, 10, 348. [Google Scholar] [CrossRef]
- Sun, H.; Zhang, F. Study on root morphological characteristics of wheat under phosphorus deficiency stress. Chin. J. Appl. Ecolocy 2002, 13, 295–299. [Google Scholar]
- Anuardha, M.; Narayanan, A. Promotion of root elongation by phosphorus deficiency. Plant Soil 1991, 136, 273–275. [Google Scholar] [CrossRef]
- Ueda, Y.; Yanagisawa, S. Perception, transduction, and integration of nitrogen and phosphorus nutritional signals in the transcriptional regulatory network in plants. J. Exp. Bot. 2019, 70, 3709–3717. [Google Scholar] [CrossRef]
- Li, Z.; Wang, Y.; Wu, X.; Zhou, L.; Li, Z.; Huang, K. Effects of phosphate fertilizer on filling characteristics and plumpness of tartary buckwheat. Acta Agric. Shanghai 2020, 36, 29–34. [Google Scholar]
Disclaimer/Publisher’s Note: The statements, opinions and data contained in all publications are solely those of the individual author(s) and contributor(s) and not of MDPI and/or the editor(s). MDPI and/or the editor(s) disclaim responsibility for any injury to people or property resulting from any ideas, methods, instructions or products referred to in the content. |
© 2024 by the authors. Licensee MDPI, Basel, Switzerland. This article is an open access article distributed under the terms and conditions of the Creative Commons Attribution (CC BY) license (https://creativecommons.org/licenses/by/4.0/).